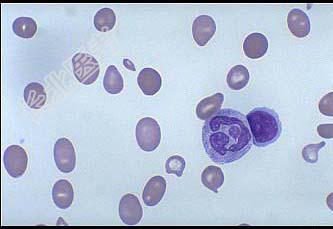

试题详情
- 多项选择题某贫血患者的血涂片、骨髓涂片、PAS染色分别如图所示,下列说法正确的是 ( )

A、该患者为大细胞正色素性贫血
B、MCV升高,MCH升高,MCHC正常,RDW升高
C、这类贫血患者血涂片上可见点彩红细胞、H-J小体及有核红细胞
D、细胞内外铁均增高
E、白细胞数正常或减低
关注下方微信公众号,搜题查看答案

热门试题
- 1、为明确诊断,需要进行的检查是(
- 1、最可能的诊断是( )。A、急性白
- 1、为明确诊断,首选的实验室检查有(
- 下列描述哪些组合是正确 ( )A、失血
- 如图,圈中所示红细胞绝对值减少见于下列哪
- 肝脏和内皮细胞均能合成的血液凝固调节蛋白
- 诊断ITP时,一般用下列哪项指标A、血小
- 在基因诊断中常用于证明骨髓中存在BCR/
- 铁染色观察计数的细胞为A、原始红细胞B、
- 醋酸AS-D萘酚醋酶(AS-D NAE)
- 关于嗜酸性粒细胞生理性变化,正确的是A、
- 临床上G-6-PD缺陷症分为A、蚕豆病B
- 1、孕妇PT缩短提示( )。A、外源
- 1、该患者凝血时间延长的原因是( )
- 周围血液中出现幼稚粒细胞见于下列哪些疾病
- Fe2+在肠黏膜的吸收主要受下列哪些因素
- 1、诊断考虑的疾病有2、为明确诊断需做的
- 对鉴别真性红细胞增多症和继发性红细胞增多
- 如图所示的异常红细胞可见于哪些疾病 (
- 凝血共同途径中的凝血因子为( )。A